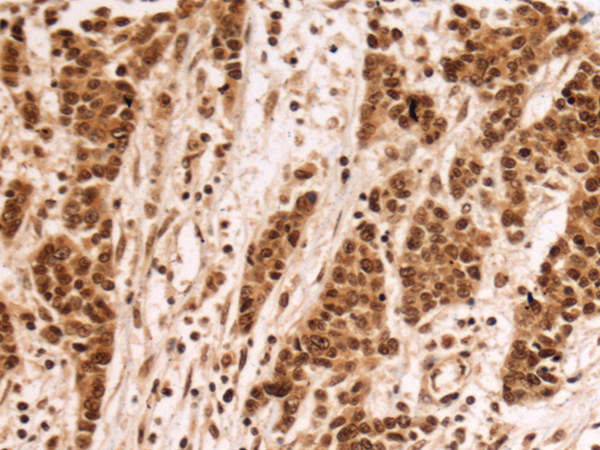

Background:
Members of the F-box protein family, such as FBXL17, are characterized by an approximately 40-amino acid F-box motif. SCF complexes, formed by SKP1 (MIM 601434), cullin (see CUL1; MIM 603134), and F-box proteins, act as protein-ubiquitin ligases. F-box proteins interact with SKP1 through the F box, and they interact with ubiquitination targets through other protein interaction domains (Jin et al., 2004 [PubMed 15520277]).[supplied by OMIM, Mar 2008]
Applications:
ELISA, IHC
Name of antibody:
FBXL17
Immunogen:
Fusion protein of human FBXL17
Full name:
F-box and leucine rich repeat protein 17
Synonyms:
Fbl17; Fbx13; FBXO13
SwissProt:
Q9UF56
ELISA Recommended dilution:
5000-10000
IHC positive control:
Human colorectal cancer and Human esophagus cancer
IHC Recommend dilution:
100-300

購物車
購物車 幫助
幫助
 021-54845833/15800441009
021-54845833/15800441009
